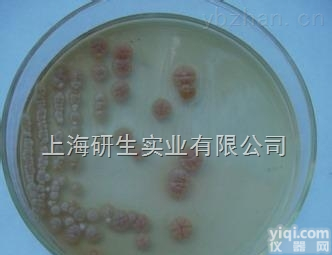
盘<em>多毛</em>孢属<em>菌种</em>生长条件

茶褐斑拟盘多毛孢价格,ATCC菌种
- 品牌:ATCC
- 产地:进口/国产
- 供应商:上海研生实业有限公司
- 供应商报价:面议
- 标签:茶褐斑拟盘多毛孢价格,ATCC菌种,1100,上海研生实业有限公司
| 品牌 | 其他品牌 | 货号 | YS-JZ0105 |
|---|---|---|---|
| 规格 | 详见说明书 | 供货周期 | 现货 |
| 主要用途 | 科研 |
茶褐斑拟盘多毛孢价格,ATCC菌种产品信息:
资源名称 茶褐斑拟盘多毛孢
种属 Pestalotiopsis guepinii
提供形式 斜面培养物
安全等级 1
模式菌株 no
培养方法
培养基 0014
生长条件 25℃
茶褐斑拟盘多毛孢价格,ATCC菌种订购说明:
我司提供的菌株皆为新培育的,能保证其基本的灵活性和活跃度,客户如需订购可提前下单,这样我们才能百分百地将全新批次产品送到您的手上,本页面可以寻到我司的,客户需要进一步了解详情的,洽谈!
种子制备的过程:
⒈ 孢子制备
⑴ 放线菌孢子的制备 放线菌的孢子培养一般采用琼脂斜面培养基,培养基中含有一些适合产孢子的营养成分,如麸皮、豌豆浸汁、蛋白胨和一些无机盐等。放线菌斜面的培养温度大多数为28 ℃,少数为37 ℃,培养时间为5~14天。
⑵ 霉菌孢子的制备 霉菌的孢子培养,一般以大米、小米、玉米、麸皮、麦粒等天然农产品为培养基。霉菌的培养一般为25~28 ℃,培养时间为4~14天。
⒉ 种子制备
⑴ 摇瓶种子制备 某些孢子发芽和菌丝繁殖速度缓慢的菌种,需将孢子经摇瓶培养成菌丝后再进入种子罐,这就是摇瓶种子。
⑵ 种子罐种子制备 种子罐种子制备的工艺过程,因菌种不同而异,一般可分为一级种子、二级种子和三级种子的制备。
3.种子培养
⑴ 表面培养法
针对容器内培养基物态又分为液态表面培养和固体表面培养。相对于容器内培养基体积而言,表面积越大,越易促进氧气由气液界面向培养基内传递。
⑵ 固体培养法
固体培养又分为浅盘固体培养和深层固体培养,统称为曲法培养。
(3)液体深层培养
液体深层种子罐从罐底部通气,送入的空气由搅拌桨叶分散成微小气泡以促进氧的溶解。其特点是容易按照生产菌种对于代谢的营养要求以及不同生理时期的通气、搅拌、温度与培养基中氢离子浓度等条件,选择适宜的培养条件。
茶褐斑拟盘多毛孢价格,ATCC菌种更多产品:
胰酪胨大豆琼脂培养基(β-内酰胺酶)90mm 10 个/包 乳酸乳球菌乳酸亚种
小皮伞 松生拟层孔菌
短波单胞菌 玫瑰产色链霉菌
白色念珠菌冻干粉 苏云金芽胞杆菌励木亚种Bacillusthuringiensissubsp.tochigiensis
停乳链球菌 茯苓
土曲霉 粉红寄生菌
玫瑰红钠琼脂培养基70mm 蛾微杆菌 ATCC 8365
北京棒杆菌 树状微杆菌 ATCC 4358
纤维纤维微菌 变异链球菌 ATCC 25175
郎比可假丝酵母 施氏假单胞菌
鼠伤寒沙门菌ATCC13311冻干粉 粘质沙雷氏菌
淡天蓝色链霉菌 噬糖盐红菌
短密青霉 肺炎克雷伯菌ATCC700603冻干粉
豌豆根瘤菌 费氏志贺氏菌
苏云金芽胞杆菌蜡螟亚种Bacillusthuringiensissubsp.galleriae 苏云金芽孢杆菌戈尔斯德变种
3-磷酸甘油醛脱氢酶(GAPDH)
3-磷酸甘油酸钠盐(PGA)
4×Native-PAGE protein loading buffer
40%PAA(19:1)
茶褐斑拟盘多毛孢价格,ATCC菌种COSIMOSIL πNAP HPLC柱萘键合的型柱子
COSMOSIL 5PBB富勒烯分析柱
COSMOSIL 5PBB-R富勒烯分析液相HPLC柱
COSMOSIL® 5PYE, 5NPE液相HPLC柱